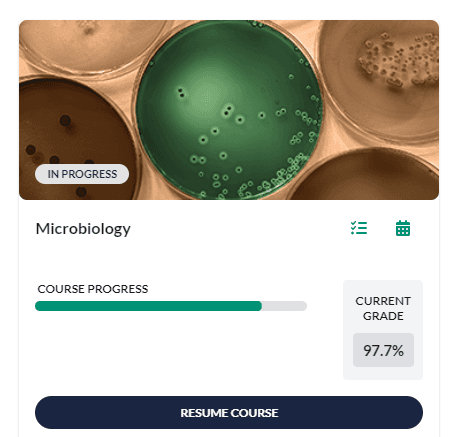
Microbiology

Academic Care, Delivered with Precision and Compassion.
Your trusted partner for university assignments, essays, and full course support. A confidential environment where competence meets care.

Assignments
Focused assistance for daily homework, problem sets, and short-turnaround tasks.
Essay & Research Papers
In-depth structuring, editing, and development for complex papers and theses.
Full Course Completion
Comprehensive management of entire online classes, ensuring steady progress weekly.
Capstones & Projects
Specialized, long-term support for critical final projects and dissertations.
Clinical Evidence

Outcome
Anatomy And Physiology 1

Outcome
Anatomy And Physiology 1 Lab

Outcome
Economics 7400 Discussions

Outcome
Chemistry 1 Lab

Outcome
Introduction to Psychology

Outcome
Microbiology Lab

Outcome
Microbiology

Outcome
ATI TEAS Exam

Outcome
Graduate Record Examinations
Patient Recoveries // Testimonials
"Thank you I can not express enough how grateful i am that you both were able to assist me! You both were very responsive, communicating, & patient with me during this entire process."
"I truly appreciate you both for making this easy for me. Thank you again and i have you saved for when i need you next time!"
"Thank you so much. Appreciate you, I have so much on my plate and you made it so much easier for me."
Ready to discuss your academic health?
Initiate a confidential, no-obligation chat with our Care Coordinators. We are here to listen and assess your needs.
Strictly confidential. No automated bots.